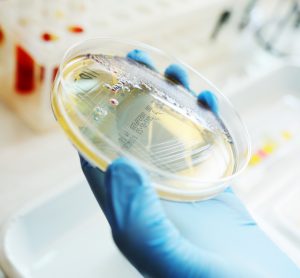

Advancing NOX inhibitors for treating fibrotic diseases and cancer
This article explores the benefit of NOX inhibitors for fibrotic diseases and cancers and highlights the potential of Calliditas Therapeutics’ drug setanaxib, including its application in wider related indications.